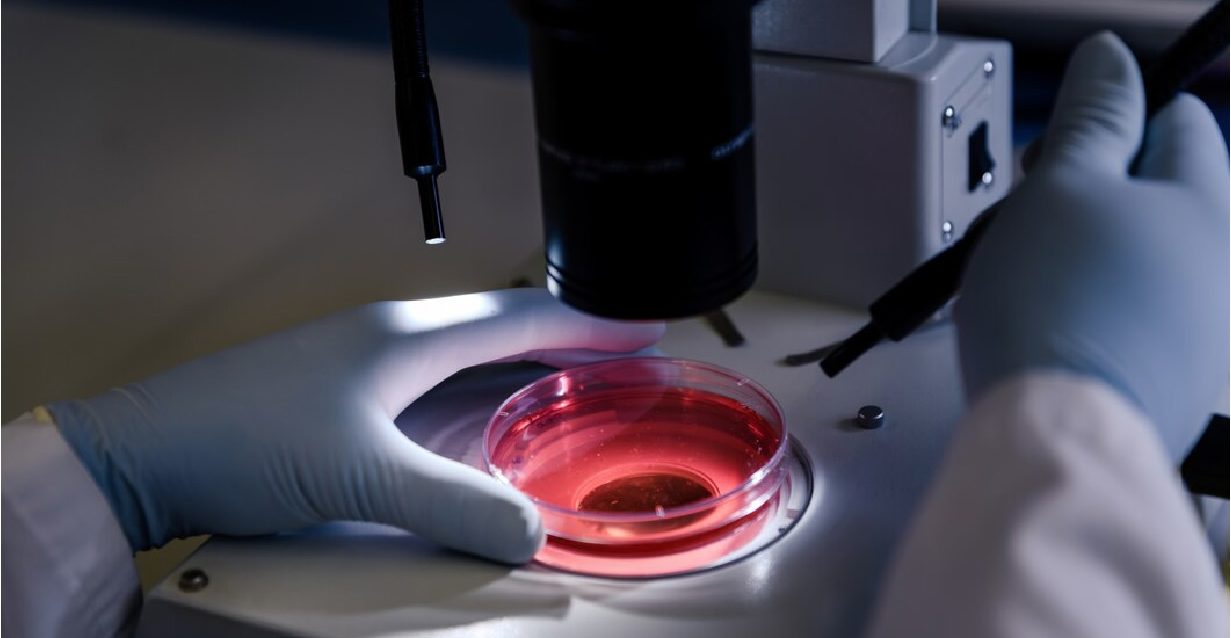
Congresso da sociedade portuguesa de microscopia será realizado em setembro Congresso da sociedade portuguesa de microscopia será realizado em setembro

The Microscopy at the Frontiers of Science Conference 2025 has established itself as a reference event in the field of microscopy, attracting international researchers and fostering interdisciplinary exchange. It is structured around three main areas within microscopy: Materials, Life Sciences, and Cryo-electron microscopy (CryoEM).
Electron Microscopy Course 2025
The Electron Microscopy Course powered by INL presents a programme focused on developing a basic understanding of the principles and operation of electron microscopy techniques.
The 13th Asia Pacific Microscopy Congress 2025
An Immersive Week The Electron Microscopy Course powered by INL presents a programme focused on developing a basic understanding of the principles and operation of electron microscopy techniques. Five Days of Advanced Training at INL’s State-of-the-Art Facilities.
5th International Workshop of In Situ Electron Microscopy
The 5th International Workshop of In situ Electron Microscopy highlights the latest advancements in in situ and in operando electron microscopy, where materials and processes are observed in real-time under controlled conditions at the atomic or nanoscale.
Microscopy and Microanalysis 2025
2025 Meeting Details Coming Soon!
Congresso da sociedade portuguesa de microscopia será realizado em setembro
O XLVI Congresso anual da Sociedade Portuguesa de Microscopia (SPMicros) será realizado este ano em 24 e 25 de
setembro, nas instalações do Hospital D. Estefânia, em Lisboa.
Sociedade Portuguesa de Microscopia celebra 50 anos no ICBAS
Os investigadores Susan Cox (King’s College London) e Paulo Ferreira (University of Texas at Austin) são alguns dos
nomes que vão marcar presença no evento.
Conferência Microscopia nas Fronteiras da Ciência edição de 2023
A edição de 2023 da Conferência Microscopia nas Fronteiras da Ciência reunirá um grupo internacional de especialistas
para discutir os últimos avanços e desenvolvimentos futuros na área.
Conferência “Microscopia nas Fronteiras da Ciência (MFS)”
Evento internacional focado na microscopia eletrónica e o seu impacto.
Homenagem de 100 anos de Miguel Mota
Uma homenagem no centenário do nascimento.